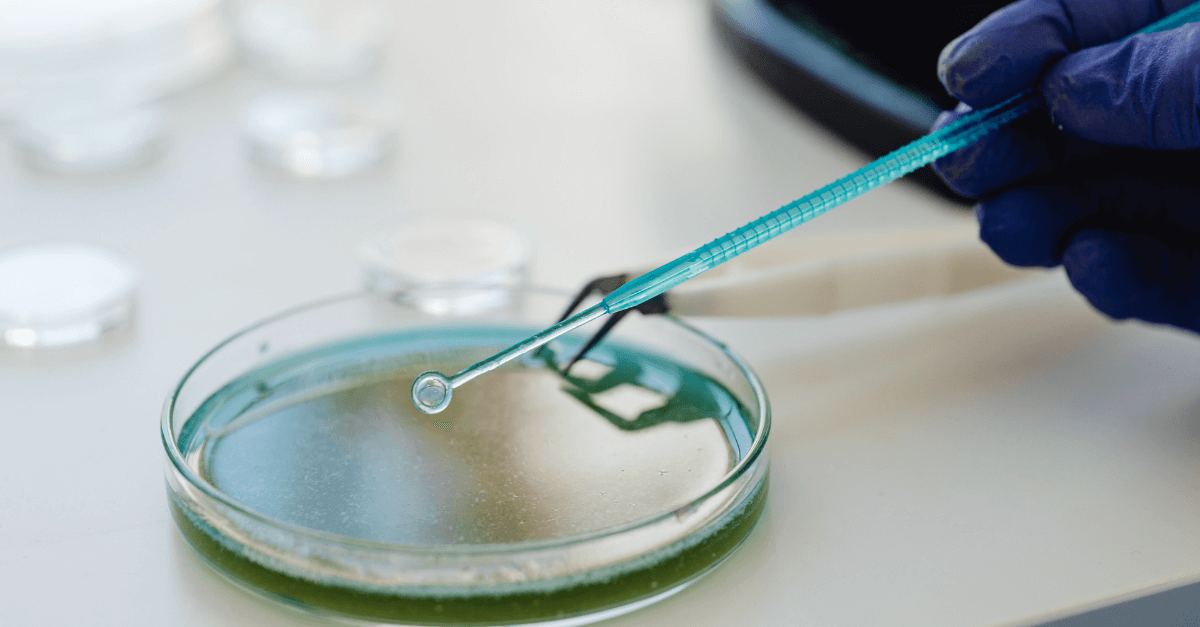
A scientist holds a sample over a dish

The regulatory landscape for preclinical testing is evolving rapidly as agencies worldwide adapt to scientific advances and increasing demands for transparency, efficiency, and patient safety. Staying ahead of these emerging regulatory trends is essential for biotech sponsors and CROs aiming to design compliant, robust preclinical programs that accelerate clinical development and regulatory approval.
Regulatory bodies like the FDA and EMA are increasingly encouraging the use of New Approach Methodologies (NAMs) — including in vitro models, organoids, and computational toxicology — to reduce animal testing while ensuring safety and efficacy. Guidance documents now reflect openness to integrated approaches combining traditional and innovative models.
2. Data Integrity and Transparency
There is a growing focus on data quality, reproducibility, and transparency throughout the preclinical lifecycle. Regulators expect detailed documentation of study design, data processing, and analytical methods to facilitate thorough review and build confidence in submitted data.
3. Enhanced Data Reporting Standards
Standardized data formats and reporting guidelines such as SEND (Standard for Exchange of Nonclinical Data) are becoming mandatory, enabling efficient data sharing and regulatory review. Early adoption of these standards can streamline submissions and reduce review cycles.
4. Integration of AI and Digital Tools
Agencies are exploring how artificial intelligence (AI) and machine learning can be leveraged in data analysis and reporting, while emphasizing the need for explainability and validation of AI-driven models in preclinical contexts.
5. Focus on Translational Relevance
Regulators are placing more weight on the translational relevance of preclinical models to human biology, encouraging use of biomarkers and mechanistic endpoints that better predict clinical outcomes.
At InfinixBio, we stay at the forefront of regulatory guidance and industry best practices to help sponsors design preclinical programs that meet evolving expectations. Our expertise includes:
Partnering with InfinixBio means you have a trusted collaborator who understands the regulatory landscape and can help you navigate it confidently.
Stay ahead of regulatory changes in preclinical testing.
Contact InfinixBio to discuss how we can tailor your preclinical program for compliance, scientific rigor, and accelerated development.
Our experienced lab team is here to help. Reach out today to learn more.